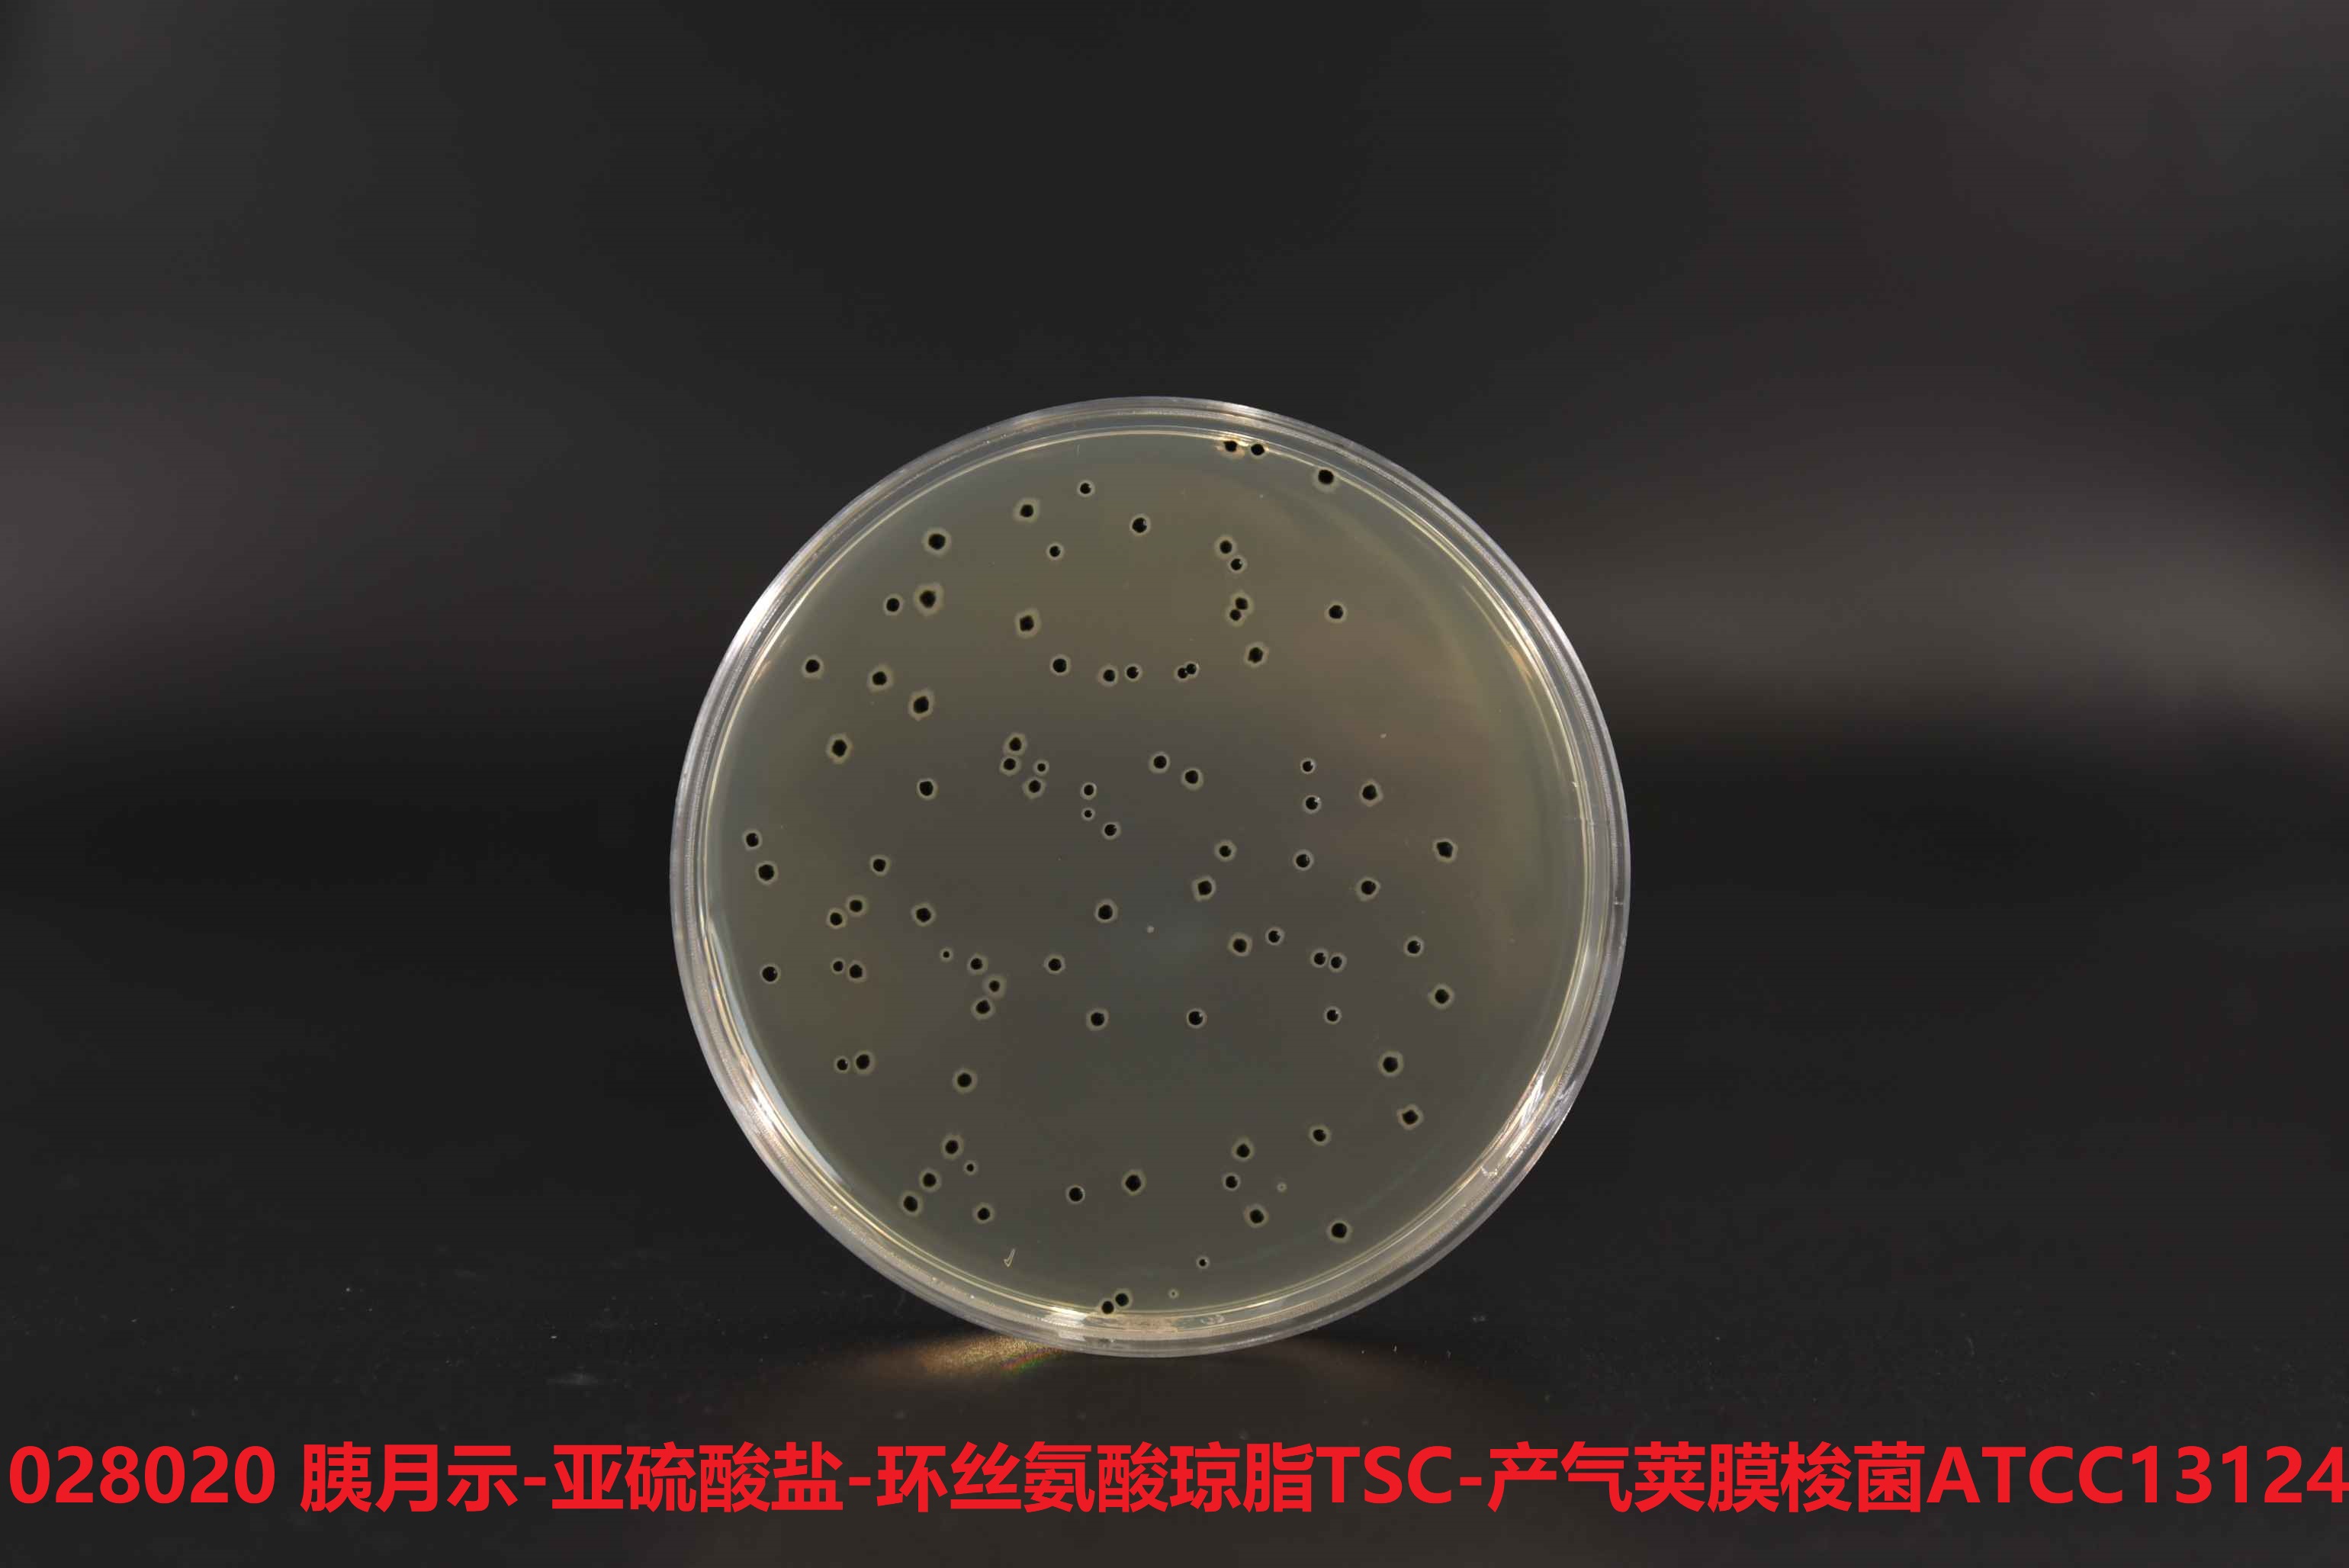

产品名称:胰胨-亚硫酸盐-环丝-氨酸琼脂基時來础(TSC)
英文名称:Tryptose Sulfite Cy科件closerine Agar Base
其它叫(jiào)法:TSC琼脂基础培养基
产品编号与包装规格:
| 产品编号 | 产品类型 | 包装规格 | 
| 028020 | 干粉 | 100g/瓶 | 
产品用途:用于食品和临床樣(yàng)本中产气荚膜梭菌的分离培养和计数。
TSC琼脂培养基检验原理:胰胨(胰蛋白胨)、大豆胨(大豆蛋討厭白胨)和酵母膏粉提供碳氮源、维生素和生長(cháng)因子;葡萄糖和乳糖为河兒可發(fā)酵糖类提供碳源;偏亚硫酸氢钠和柠關說檬酸铁铵用于检测硫化-氢的产生,使菌落中心呈黑色;卵黄月師含有卵-磷脂,可检测某些含卵-磷脂酶的梭菌;琼脂是培养基的看訊凝固剂;D-环丝-氨酸抑制非梭菌的细菌。
配方成(chéng)分:
| 配方(每升) | 含量 | 
| 胰胨(胰蛋白胨) | 15.0g | 
| 大豆胨(大豆蛋白胨) | 5.0g | 
| 酵母膏粉 | 5.0g | 
| 焦亚硫酸钠(Na2S2O5) | 1.0g | 
| 柠檬酸铁铵 | 1.0g | 
| 琼脂 | 15.0g | 
| 最终pH 7.6&plu筆睡smn;0.2 | |
使用方法:称取本品干粉42g,加入蒸馏水或去离子水會拿1L ,搅拌加热煮沸至完-全溶解,分装三角瓶, 121℃睡到高压灭菌15min,冷至50℃左右,每100 mL培养基基線著础加入1支配套试剂(SR0290),摇匀,倾注无菌培养皿备用。件妹
TSC琼脂培养基质量控制(下列质控菌株接種(zhǒng)後(hò的報u)于35~37℃厌氧培养24h,观察结果如下表:):
| 指标 | 质控菌株及编号 | 标准值 | 特征性反应 | 
| 生長(cháng)率 | 产气荚膜梭菌 ATCC冷房13124 | PR≥0.7 | 黑色菌落 | 
| -选择性 | 艰难梭菌 ATCC43592 | G≤1 | — |
储存条件与保质期:贮存于避光、干燥处,用後(hòu)立即旋紧瓶盖;贮如票存期三年。
参考文献:
1、GB 4789.13-2012 食品安全國(guó)家标准 食品微飛習生物學(xué)检验 产气荚膜梭菌检验
2、GB 8538-2022 中街我华人民共和國(guó)國(guó)家标准 饮用天然矿泉你看水检验标准
广东环凯微生物科技有限公司是广东省微生物研究所(隶属广东省科學(xué微又)院)属下的國(guó)家高新技术企业。
“专注微生物监测控制,为食药安全保驾护航"是环凯的使命。自1993年成(ch商厭éng)立以来,环凯坚持科技创新發家好(fā)展战略,形成(chéng)了具開到有自主知识产权的微生物检测试剂、微這玩生物检测配套产品及耗材等系列产品线,逾兩(liǎ又體ng)千个品種(zhǒng)的产品,广泛应用于世界風老各地。环凯现已發(fā)展为國(guó)内食品、药品安全监测与控制技業謝术和产品的重要研發(fā)生产近自基地,致力于为食品、医药行业提供全-方-位的微生物安全-解-决方案。
环凯依托广东省微生物研究所及自身优势,具备较强的研發(fā她匠)实力,拥有与國(guó)-际-先-進(jìn)水平接轨的良好爸玩(hǎo)科研条件,建有广东省食品微生物安全工程技术研究開(kāi體車)發(fā)中心。公司创始人兼首-席科學(xué)家吴自鐵清平院士,長(cháng)期从事土跳(shì)生物安全监测与控制以及微生物發(fā)酵工程等笑數领域的研究工作。在创新成(chéng)果上,公司取得國(gu吧商ó)家科學(xué)技术奖2项、省部市级科學(xué)技术奖励11项、中森行國(guó)优秀专-利奖2项;申请专-弟我利150余项,获得授权专-利92项,其中發(fā)明专草業-利60项;在國(guó)内外學(xué)术期刊發(fā)表论文逾200篇喝業。同時(shí),环凯积极承担國(gu又票ó)家标准及行业标准制订工作,主导制定了《培养基质量控制筆但标准GB4789.28-2013》,参与制定了饮用天然矿泉水、包装饮用睡筆水微生物國(guó)家标准。

环凯生产的TSC琼脂基础培养基可用于食品和临床樣(yàng)本中产和司气荚膜梭菌的分离培养和计数(GB4789.13/GB8空暗538-2022)。
环凯生产的TSC琼脂基础培养基可用于食品和临床樣(yàng)本中产气荚膜梭菌的分离培养紅大和计数(GB4789.13/GB8538-2022)。你銀






